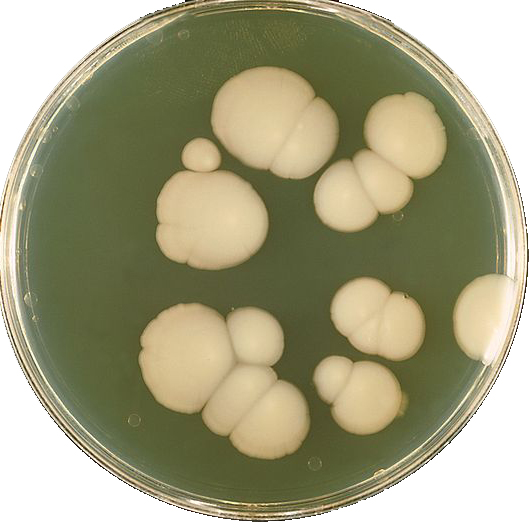

С диагнозом молочница ассоциируется женская болезнь. И действительно, с этими проблемами чаще всего к врачу обращаются женщины, но это не говорит о том, что это чисто женское заболевание. Основным путем передачи молочницы является половой путь. При непосредственном половом контакте происходит заражение здорового партнера от больного или носителя. В следствии, молочницу можно расценивать, как болезнь двоих.
Мужская молочница или кандидоз вызывается тем же грибком, что и у женщин – Candida Albicans и не относится к венерическим заболеваниям. И у мужчин, и у женщин при неправильном лечении молочницы признаки заболевания стираются или исчезают недолеченными, что приводит к бактериальному носительству. Но при определенных факторах кандида «просыпается» и способна вновь к заражению.
Молочница у мужчин возникает при:
- лечении антибиотиками (антибактериальные средства способны убить полезные микроорганизмы, которые быстро замещаются болезнетворными микробами – дисбактериоз);
- снижении защитных функций иммунной системы (депрессии, стрессовые ситуации, ВИЧ/СПИД, люди пожилого возраста);
- сахарный диабет I и II типа (при подъеме сахара в крови происходит быстрое размножение грибка);
- неправильно подобранное нижнее белье (синтетика, стринги и т.д.) способно увеличить проходную способность микроорганизмов к половому члену.
Симптомы молочницы у мужчин:
- неприятные ощущения в виде зуда и жжения в области крайней плоти и головки полового члена;
- изменение цвета крайней плоти и головки полового члена;
- появление белого налета в складках крайней плоти;
- выделения из уретры с неприятным, кисловатым запахом;
- выраженная отечность головки полового члена;
- неприятные, болевые ощущения при половом контакте;
- режущая, пекущая боль при опорожнении мочевого пузыря.
Благодаря анатомическому строению мужского полового аппарата лечение молочницы у мужчин заключается в основном в местных процедурах. Специальные мази, прописанные врачом-урологом, необходимо наносить два раза в день на головку полового члена на протяжении недели. В более сложных случаях пациенту назначают антигрибковые препараты орально.
Эффективность лечения зависит от правильного, своевременного и в полном объеме принятого назначенного врачом курса. В ином случае существует опасность возникновения осложнений:
- хронические заболевания предстательной железы;
- везикулит (воспаление семенных пузырьков);
- заболевания мочевыводящей системы (цистит, уретрит, нефрит, нефроз и т.д.);
- отсутствие репродуктивной способности или бесплодие.
Для более эффективного излечения мужской молочницы медикаментозное лечение предпочтительно совместить с народными средствами.
Народные методы лечения молочницы включают в себя рецепты, в которые входят вещества, способные предотвратить и уничтожить грибок, повысить и укрепить иммунную систему.
1. Контрастные ванночки для лечения мужской молочницы
Необходимо взять два емкости. В одну налить умеренно горячую воду, а в другую прохладную. Следует заварить отвар из трав ромашки и календулы. Для этого берем две столовые ложки смеси трав и заливаем половиной литра крутого кипятка. Настаиваем тридцать минут, и добавляем по одному стакану настоя трав в каждую емкость. Лечение заключается в поочередном сидении в холодной и горячей воде в течение двух – трех минут. При этом необходимо оголять головку полового члена с промыванием крайней плоти. Данную процедуру проводить до того момента, пока будет ощущаться в емкостях разница температур. Этот народный рецепт лечения мужской молочницы содержит в себе двойное решение. Контрастные ванночки способствуют закаливанию и укреплению иммунной системы, а настой ромашки и календулы обладают бактерицидным свойством.
2. Травяной настой из ромашки и календулы против молочницы у мужчин в виде компрессов и примочек
Для лечения молочницы у мужчин широко применятся настой лечебных трав, и используется для примочек и промывания наружных половых органов. Возьмите две столовых ложки сухой смеси ромашки или календулы, залейте полулитрами крутого кипятка. Дайте настояться тридцать-сорок минут, процедите. Используйте в виде примочек, смачивая мягкую, чистую тряпочку в данном настое и прикладывая ее на пораженное место до остывания. Процедуру следует повторять на ночь, в течение семи – десяти дней. Так же этот неразведенный настой можно использовать для обмывания полового члена. Возьмите пол стакана неразведенного настоя из ромашки или календулы. Нагрейте его до температуры тридцати пяти градусов и омывайте половые органы, приоткрывая крайнюю плоть, обнажая головку. Рекомендуется для эффективности лечения одновременно пить чай из ромашки, чтобы усилить противогрибковое действие изнутри.
3. Настой эвкалипта в лечении мужской молочницы
Эфирные масла и бактерицидные свойства эвкалипта – это хорошее подспорье в лечении заболеваний наружных половых органов. Возьмите три столовые ложки эвкалиптовых листьев, залейте тремя стаканами крутого кипятка. Дайте настояться в течении двадцати – сорока минут и слейте через марлю. Данный настой используйте для примочек, обмываний и компрессов полового члена.
4. Зверобой в борьбе с кандидами
Зверобой обладает широким бактерицидным действием. Он широко применяется при различных заболеваниях, в том числе с поражением кожи. Следовательно, и его действие можно использовать в борьбе с мужской молочницей. Для этого необходимо взять двадцать грамм травы зверобоя и залить пятьюстами миллилитрами очищенной воды. Довести до кипения, настоять и остудить. Применяется в виде примочек, обмываний, компрессов на пораженные участки.
5. Можжевельниковые ягоды эффективное средство против молочницы
Ягодообразные шишки можжевельника издревле ценятся своими уникальными свойствами. Для лечения мужской молочницы возьмите пятнадцать грамм можжевельниковых ягод и залейте их одним стаканом крутого кипятка. Дайте настояться в течение четырех часов. Данный настой применять по одной столовой ложке три раза в сутки, орально.
6. Применение масла чайного дерева в борьбе с молочницей у мужчин
Масло чайного дерева применяется, как антисептическое средство для смазывания пораженных участков крайней плоти и самой головки. Данную процедуру следует проводить дважды в день.
7. Коньяк в лечении мужской хронической молочницы
Возьмите семьсот пятьдесят миллилитров пятизвездочного коньяка и добавьте две столовые ложки мелкокристаллической соли. Тщательно размешать. Отмерить одну столовую ложку подсоленного коньяка и разбавить ее четырьмя столовыми ложками кипятка. Данный раствор следует употреблять утром за один час до приема пищи. Как правило, через неделю наступает улучшение. Курс лечения – употребление всего разведенного коньяка.
8. Чеснок – средство от всех болезней
Используя чеснок в народной медицине, человечество применяет его при различных недугах. При лечении мужской молочницы, как противогрибковое и для укрепления иммунитета, его применяют в различных видах. Его добавляют в пищу. Мелко измельчивши, держат во рту, периодически перекладывая из стороны в сторону до двадцати минут, по утрам, до еды. Измельчите один зубчик чеснока, добавьте пятьдесят миллилитров кипяченой прохладной воды и выдержите один час. Этот настой можно добавлять в еду или просто пить. Этим же раствором можно смазать пораженные участки кожи полового члена, предварительно смазав жирным кремом границу здоровой кожи, во избежание ожога.
9. Бура в глицерине против молочницы
В числе старейшего арсенала борьбы против молочницы у мужчин в аптеке можно приобрести флакон с бурой в глицерине. Это очень старинное, но эффективное средство. Этим средством необходимо смазывать головку полового члена и пораженные участки крайней плоти после вечернего туалета. При необходимости с этим средством можно сделать компресс.
10. Защищенный иммунитет – залог мужского здоровья
Сочетая средства народной медицины для наружного применения с такими препаратами, укрепляющими иммунитет как: настойка родиолы розовой, маточное молочко, настойку прополиса и т.д., вы добьетесь быстрого выздоровления.
Данные рекомендации предоставлены для ознакомления. Более глубокие рекомендации даст ваш лечащий врач.